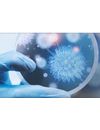

- Home
- Companies
- Bertin Technologies
- Applications
Bertin Technologies applications
Spectrometric monitoring offers a continuous operating measurement system for nuclide specific detection of low level gamma contamination in air and in liquids.
The Coriolis air sampler collects biological particles in the air for biosphere and environmental air quality control
Coriolis air sampler collects biological particles in the air for biocontamination control in a biomedical and health environment
Coriolis air sampler collects biological particles in the air for fundamental research on biological airborne particles
Coriolis RECON, a portable, light and ruggedized bio-air sampler, collects biological warfare agents in the air for bio surveillance purposes.
Coriolis RECON, a portable, light and ruggedized bio-air sampler, collects biological warfare agents in the air for detection during on-site operations.
Radiation portal monitors are specifically designed for the detection of very low radioactive contamination and orphan sources at high traffic flow gates for vehicles, cargo, containers and pedestrians.
Radon monitoring for Radon calibration labs, research and expertise, specific applications (seismic survey, and so on)
Radon monitoring equipment for Radon risk assessment in NORM and nuclear industries (mining, nuclear waste disposals, oil and gas industry, and so on).
Control of high radioactivity levels can be done only with dedicated instruments able to measure radiation up to 300 Gy/h.